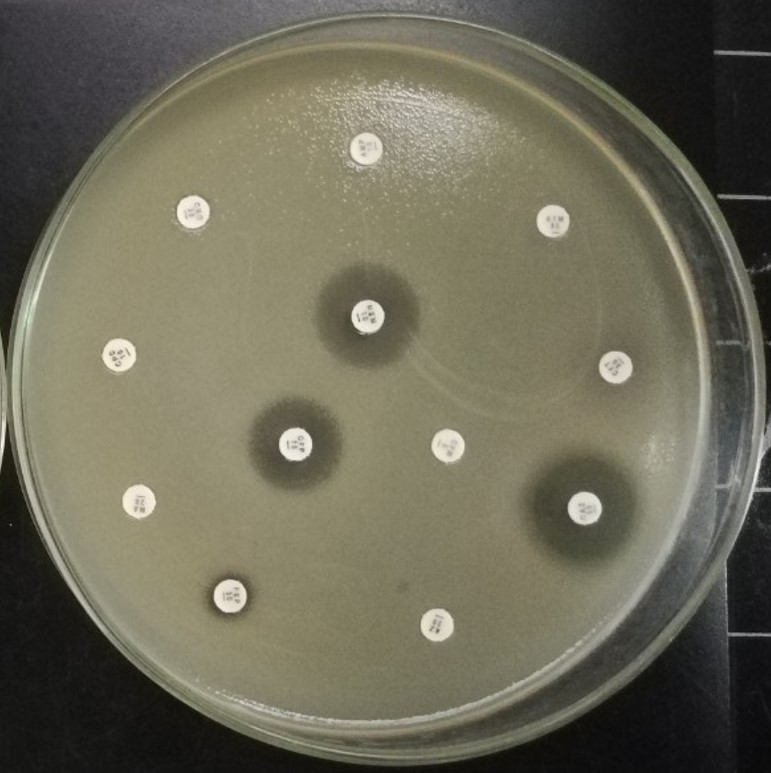

มาเข้าใจความหมายและสาเหตุของเชื้อดื้อยากันเถอะ
ดร.นิศานาถ เจริญลาภ
รองศาสตราจารย์ ดร. ร.อ. ไพบูลย์ วัฒนวิบูลย์
ศาสตราจารย์เกียรติคุณ ดร.ศกรณ์ มงคลสุข
ห้องปฏิบัติการวิจัยเทคโนโลยีชีวภาพ สถาบันวิจัยจุฬาภรณ์
ปัจจุบันนี้ การดื้อยาเป็นเรื่องที่กำลังได้รับความสนใจเป็นอย่างมาก แต่จะมีสักกี่คนที่จะเข้าใจในความหมายของคำว่า “ดื้อยา” ได้อย่างถูกต้อง รวมถึงสาเหตุและที่มาของปัญหาที่เกิดขึ้น จึงขออธิบายความหมายของคำว่าดื้อยาและงานวิจัยทางด้านนี้ที่กำลังดำเนินการอยู่ที่สถาบันวิจัยจุฬาภรณ์ เพื่อให้คลายข้อสงสัยต่าง ๆ เหล่านี้
การดื้อยาที่พูดถึงกัน ส่วนมากมีความหมายถึงการดื้อยาปฏิชีวนะ (Antibiotic Resistance) ซึ่งเป็นความสามารถของแบคทีเรียที่ทนต่อยาปฏิชีวนะชนิดใดชนิดหนึ่ง หรือมากกว่าหนึ่งชนิดก็ได้ ความสามารถนี้ไม่ใช่เรื่องใหม่ที่เพิ่งค้นพบ แต่เป็นความสามารถของแบคทีเรียที่สามารถปรับตัวให้อยู่รอดในสภาวะวิกฤตต่างๆ ได้ รวมทั้งสภาวะที่ต้องเผชิญกับยาปฏิชีวนะเช่นกัน การใช้ยาปฏิชีวนะมากเกินความจำเป็นหรือใช้อย่างไม่ถูกต้องจะทำให้แบคทีเรียมีวิวัฒนาการหรือปรับตัวให้ดื้อต่อยาปฏิชีวนะ ความสามารถดื้อต่อยาปฏิชีวนะของแบคทีเรียนี้จะไม่ใช่ปัญหาสำคัญถ้าหากอัตราการเกิดของแบคทีเรียดื้อยาที่มีความสามารถนี้ ไม่ได้เพิ่มสูงขึ้นอย่างรวดเร็วเช่นในปัจจุบัน อีกทั้งยังมีแบคทีเรียบางตัวที่มีความสามารถดื้อต่อยาปฏิชีวนะได้หลากหลายชนิด (Multidrug resistant bacteria, MDR) เรียกได้ว่า ไม่มียาปฏิชีวนะใดที่สามารถกำจัดแบคทีเรียชนิดนี้แล้ว ดังนั้น ถ้าเกิดการติดเชื้อจากแบคทีเรียนั้นๆ ก็จะไม่สามารถรักษาได้อีกต่อไป และผู้ป่วยที่ได้รับเชื้อดื้อยานั้นจะเสียชีวิตในที่สุด
อุบัติการณ์เช่นนี้เองที่ทำให้ทั่วโลกตื่นตัว และหันมาให้ความสำคัญของการศึกษาการดื้อยา ซึ่งสถาบันวิจัยจุฬาภรณ์ได้เห็นปัญหานี้เช่นกัน และได้เริ่มศึกษาวิจัยเกี่ยวกับการดื้อยามาเป็นระยะเวลาหนึ่งแล้ว โดยคาดหวังว่าผลจากงานวิจัยนี้จะเป็นประโยชน์ต่อประชาชน อันเป็นการสนองต่อพระปณิธานของศาสตราจารย์ ดร. สมเด็จพระเจ้าน้องนางเธอ เจ้าฟ้าจุฬาภรณวลัยลักษณ์ อัครราชกุมารี กรมพระศรีสวางควัฒน วรขัตติยราชนารี องค์ประธานสถาบันวิจัยจุฬาภรณ์ เพื่อให้งานวิจัยเกิดประโยชน์ต่อคนไทยและเพื่อให้คนไทยมีคุณภาพชีวิตที่ดีขึ้น
การที่จะสามารถแก้ไขปัญหาการดื้อยาได้นั้น จำเป็นต้องเข้าใจสาเหตุของปัญหาอย่างถ่องแท้เสียก่อน ยาปฏิชีวนะมีกลไกการทำงานโดยทำให้แบคทีเรียไม่สามารถเพิ่มจำนวนได้และตายในที่สุด กลไกการดื้อยาของเชื้อแบคทีเรียเกิดจาก 3 กลไก ดังแสดงในรูปที่ 1 (1) ได้แก่ 1) แบคทีเรียมีความสามารถเปลี่ยนแปลงโมเลกุลเป้าหมาย (สีเขียว) ของตัวเองให้รอดพ้นจากการจับของยาปฏิชีวนะ (สีแดง) ดังนั้น ยาปฏิชีวนะจึงไม่สามารถทำลายโมเลกุลเป้าหมายได้อีกต่อไป ส่วนมากมักเกิดจากการกลายพันธุ์ของแบคทีเรียที่ถูกเหนี่ยวนำจากการใช้ยาปฏิชีวนะที่ไม่เหมาะสม เช่น ความเข้มข้นยาปฏิชีวนะที่ต่ำเกินไป หรือระยะเวลาที่ใช้ยาปฏิชีวนะน้อยเกินไป ไม่ครบตามปริมาณที่กำหนด 2) แบคทีเรียสามารถผลิตเอนไซม์ที่ทำลายยาปฏิชีวนะให้หมดฤทธิ์ได้ (สีส้ม) 3) แบคทีเรียสามารถลดปริมาณยาปฏิชีวนะภายในเซลล์ โดยลดความสามารถของโปรตีนที่เยื่อหุ้มเซลล์ทำให้นำเข้ายาปฏิชีวนะลดลง หรือผลิตโปรตีนขับยาปฏิชีวนะออกจากเซลล์ (efflux pump) ดังนั้น ยาปฏิชีวนะจึงไม่สามารถฆ่าแบคทีเรียได้ โดยทั่วไปแบคทีเรียดื้อยามักมีความสามารถดังกล่าวอย่างน้อยหนึ่งกลไก ซึ่งเพียงพอที่จะทำให้เกิดการดื้อยาแล้ว



รูปที่ 1
1) แบคทีเรียมีความสามารถในการเปลี่ยนแปลงโมเลกุลเป้าหมาย
2) แบคทีเรียเปลี่ยนแปลงยาปฏิชีวนะให้เสียสภาพ
3) แบคทีเรียลดปริมาณยาปฏิชีวนะภายในเซลล์
จาก Blair et al. (2015) (1)

ทั้งนี้ ห้องปฏิบัติการวิจัยเทคโนโลยีชีวภาพ
สถาบันวิจัยจุฬาภรณ์ โดย ศาสตราจารย์เกียรติคุณ
ดร.ศกรณ์ มงคลสุข รองศาสตราจารย์ ดร. ร.อ. ไพบูลย์ วัฒนวิบูลย์ และดร.นิศานาถ เจริญลาภ ได้สนใจศึกษาโปรตีนขับยาปฏิชีวนะ (Efflux pump) ในเชื้อแบคทีเรียก่อโรคในคน คือ Stenotrophomonas maltophilia คณะผู้วิจัยโดย
ดร.นิศานาถ เจริญลาภ ได้นำเสนอผลงานวิจัยนี้ในงานประชุมวิชาการกรมวิทยาศาสตร์การแพทย์ ครั้งที่ 25 และได้รับรางวัลชนะเลิศ ประเภทนำเสนอผลงานด้วยวาจา สาขา Medical Science Symposium เมื่อวันที่ 24 มีนาคม พ.ศ. 2560 บทสรุปของงานวิจัยโดยย่อมีดังนี้

เชื้อแบคทีเรีย Stenotrophomonas maltophilia จัดอยู่ในกลุ่มเชื้อฉวยโอกาสที่ก่อโรคติดเชื้อในโรงพยาบาล สามารถก่อโรคในทุกระบบของร่างกายโดยเฉพาะอย่างยิ่งระบบทางเดินหายใจ ทางเดินปัสสาวะ และการติดเชื้อในกระแสโลหิต ปัจจุบันนับว่าเป็นหนึ่งในสาเหตุสำคัญของการเสียชีวิตของผู้ป่วยจากโรคติดเชื้อในโรงพยาบาล ปัญหาสำคัญของการติดเชื้อ S. maltophilia เกิดจากการดื้อต่อยาปฏิชีวนะหลายชนิด (MDR) จากการศึกษาจีโนมของเชื้อชนิดนี้ พบว่ามียีนที่เกี่ยวข้องกับการดื้อยาอยู่เป็นจำนวนมาก ไม่ว่าจะเป็นเอนไซม์ที่ทำให้ยาเสียสภาพหรือโปรตีนขับยาชนิดต่างๆออกจากเซลล์ (2)

ห้องปฏิบัติการวิจัยเทคโนโลยีชีวภาพ ได้ศึกษาวิจัยเพื่อหาสาเหตุการดื้อต่อยาปฏิชีวนะหลายชนิดของเชื้อ S. maltophilia โดยมุ่งเน้นการดื้อยาที่เกิดจากโปรตีนขับยา วัตถุประสงค์หลักของงานวิจัยนี้เพื่อการศึกษาโปรตีนที่เป็นเป้าหมายของยา คณะผู้วิจัยสามารถแยกยีน mfsA ที่สร้างโปรตีนขับยา MfsA ซึ่งเป็นโปรตีนที่ชั้นเยื่อหุ้มเซลล์ของแบคทีเรีย (membrane protein) ที่สามารถขนส่งสารชนิดต่างๆ ผ่านเยื่อหุ้มเซลล์โดยใช้พลังงานจากโปรตอน (proton gradient) (4)
ในการวิจัยเมื่อสร้างแบคทีเรียกลายพันธุ์ที่ไม่มียีน mfsA (ΔmfsA) ทำให้แบคทีเรียมีความไว (susceptibility) ต่อยาปฏิชีวนะหลายชนิดมากขึ้น รวมถึงมีความไวต่อยาในกลุ่มฟลูออโรควิโนโลน (fluoroquinolones) (3) ซึ่งเป็นยาชนิดหนึ่งในกลุ่มยาที่มักใช้ในการรักษาการติดเชื้อจาก S. maltophilia และเมื่อเพิ่มการแสดงออกของยีน mfsA โดยใช้พลาสมิด พบว่า ทำให้เชื้อดื้อต่อยาปฏิชีวนะฟลูออโรควิโนโลน (fluoroquinolones) เพิ่มมากขึ้นหลายเท่า

จากการศึกษาทำให้ค้นพบลักษณะที่น่าสนใจของยีน mfsA โดยพบว่า การแสดงออก (expression) ของยีน mfsA จะเพิ่มขึ้นอย่างมากเมื่อเชื้อสัมผัสกับอนุมูลอิสระออกซิเจนชนิดซุปเปอร์ออกไซด์แอนไอออน (superoxide anion) เนื่องจากยีน mfsA ถูกควบคุมโดยโปรตีนควบคุม (transcriptional regulator) ที่ชื่อว่า SoxR (4) รูปที่ 2 แสดงให้เห็นว่าเมื่อ S. maltophilia สัมผัสกับซุปเปอร์ออกไซด์แอนไอออน ที่สร้างโดยเซลล์เม็ดเลือดขาวในกลุ่มแมคโครฟาจ (macrophage) ในระบบภูมิคุ้มกันชนิดทั่วไป (innate immunity) ทำให้โปรตีนควบคุม SoxR กระตุ้นการสร้างโปรตีนขับยา MfsA เพิ่มมากขึ้น อันเป็นสาเหตุให้เชื้อดื้อต่อยาปฏิชีวนะกลุ่มฟลูออโรควิโนโลน (fluoroquinolones) มากขึ้น การค้นพบนี้มีความน่าสนใจเนื่องจากยากำจัดวัชพืชพาราควอท ก็จัดอยู่ในประเภทสารที่ทำให้เกิดซุปเปอร์ออกไซด์แอนไอออนในเซลล์ได้เช่นกัน เมื่อวิเคราะห์ข้อมูลจากฐานข้อมูลทางจีโนม (National Center for Biotechnology Information – NCBI) พบว่าเชื้อ S. maltophilia ทุกสายพันธุ์มียีน mfsA ดังนั้น โปรตีนขับยา MfsA จึงเหมาะสมที่จะเป็นเป้าหมายตามสมมุติฐานที่ตั้งไว้ คือ ถ้าสามารถคัดเลือกสารที่สามารถยับยั้งการทำงานของโปรตีนขับยา MfsA ได้ เมื่อนำสารดังกล่าวมาใช้จะทำให้เชื้อแบคทีเรียกลับมาไวต่อยาปฏิชีวนะฟลูออโรควิโนโลน (fluoroquinolones) ได้เช่นเดิม ดังนั้น องค์ความรู้ที่ได้จากงานวิจัยนี้นับเป็นประโยชน์อย่างยิ่งในการพัฒนายาตัวใหม่สำหรับรักษาโรคติดเชื้อได้ในอนาคต
เอกสารอ้างอิง
1. Blair, J. M., M. A. Webber, A. J. Baylay, D. O. Ogbolu, and L. J. Piddock. 2015. Molecular mechanisms of antibiotic resistance. Nat Rev Microbiol 13:42-51.
2. Crossman, L. C., V. C. Gould, J. M. Dow, G. S. Vernikos, A. Okazaki, M. Sebaihia, D. Saunders, C. Arrowsmith, T. Carver, N. Peters, E. Adlem, A. Kerhornou, A. Lord, L. Murphy, K. Seeger, R. Squares, S. Rutter, M. A. Quail, M. A. Rajandream, D. Harris, C. Churcher, S. D. Bentley, J. Parkhill, N. R. Thomson, and M. B. Avison. 2008. The complete genome, comparative and functional analysis of Stenotrophomonas maltophilia reveals an organism heavily shielded by drug resistance determinants. Genome Biol 9:R74.
3. Dulyayangkul, P., N. Charoenlap, K. Srijaruskul, S. Mongkolsuk, and P. Vattanaviboon. 2016. Major facilitator superfamily MfsA contributes to multidrug resistance in emerging nosocomial pathogen Stenotrophomonas maltophilia. J Antimicrob Chemother 71:2990-1.
4. Srijaruskul, K., N. Charoenlap, P. Namchaiw, S. Chattrakarn, S. Giengkam, S. Mongkolsuk, and P. Vattanaviboon. 2015. Regulation by SoxR of mfsA, Which Encodes a Major Facilitator Protein Involved in Paraquat Resistance in Stenotrophomonas maltophilia. PLoS One 10:e0123699.








